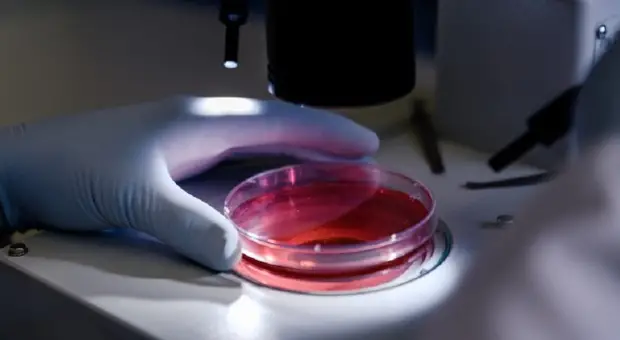

s
Estero
Donatore di sperma ha una mutazione genetica che aumenta il rischio di cancro, nati 200 bambini: «Alcuni sono già morti»
Ieri 10-12-25, 15:34
Quasi 200 bambini concepiti in 14 Paesi europei con lo sperma di un donatore portatore di una mutazione genetica nel gene TP53, che aumenta drasticamente il rischio di tumori, inclusa la rara...
CONTINUA A LEGGERE

5

0

0










